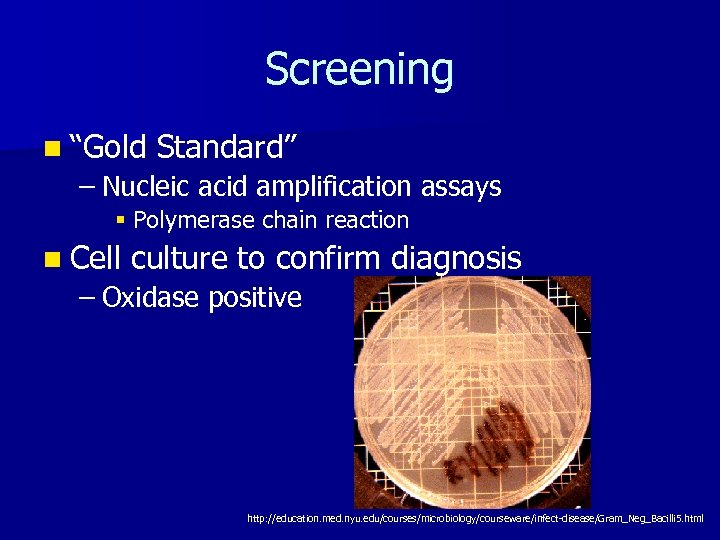
Screening n “Gold Standard” – Nucleic acid amplification assays § Polymerase chain reaction n
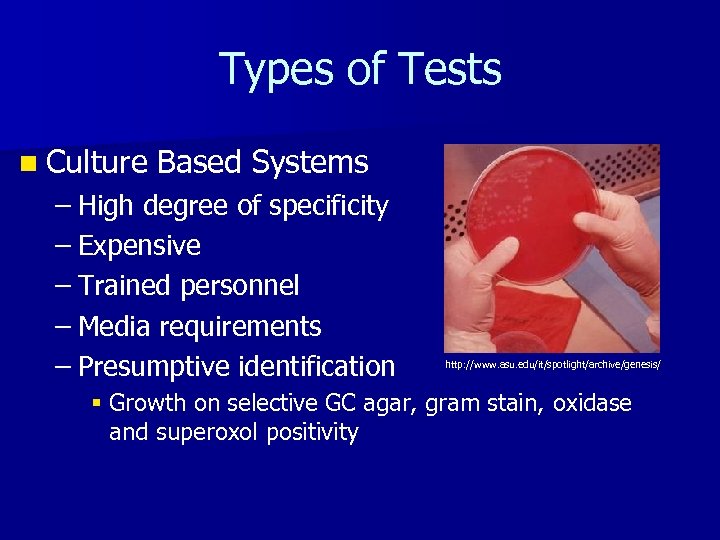
Types of Tests n Culture Based Systems – High degree of specificity – Expensive

7ee98b2a3461e8d0bbe5142d6e5449a2.ppt
- Количество слайдов: 40
 Neisseria gonorrhoeae Nealia House
Neisseria gonorrhoeae Nealia House
 Gonorrhea n Topic Overview n Biology of Neisseria gonorrhoeae – Survival Within Host n Screening n Treatment n Control/Surveillance http: //www 2. chemie. unierlangen. de/education/medchem/harnsteine/urs_infektion. html
Gonorrhea n Topic Overview n Biology of Neisseria gonorrhoeae – Survival Within Host n Screening n Treatment n Control/Surveillance http: //www 2. chemie. unierlangen. de/education/medchem/harnsteine/urs_infektion. html
 Gonorrhea n Sexually transmitted disease n Infection Rate – socioeconomic class – Age n Very common infectious disease – STI second only to chlamydia n Increasing antibacterial resistance n Increases efficiency of HIV transmission http: //www. cat. cc. md. us/courses/bio 141/labmanua/lab 1/dkngon. html
Gonorrhea n Sexually transmitted disease n Infection Rate – socioeconomic class – Age n Very common infectious disease – STI second only to chlamydia n Increasing antibacterial resistance n Increases efficiency of HIV transmission http: //www. cat. cc. md. us/courses/bio 141/labmanua/lab 1/dkngon. html
 Affected Populations STI Rates World-Wide http: //www. agi-usa. org/pubs/ib_std. html
Affected Populations STI Rates World-Wide http: //www. agi-usa. org/pubs/ib_std. html
 Gonorrhea n Humans host only natural – Reproductive tract n Infection can be asymptomatic – Infertility http: //evolution. berkeley. edu/evosite/relevance/images/Ku nkel_97210 C. jpg n Several tests available for detection of gonorrhea
Gonorrhea n Humans host only natural – Reproductive tract n Infection can be asymptomatic – Infertility http: //evolution. berkeley. edu/evosite/relevance/images/Ku nkel_97210 C. jpg n Several tests available for detection of gonorrhea
 Gonorrhea n Topic Overview n Biology of Neisseria gonorrhoeae – Survival Within Host n Screening n Treatment n Control/Surveillance http: //www. nature. com/genomics/images/neisseria_200. jpg
Gonorrhea n Topic Overview n Biology of Neisseria gonorrhoeae – Survival Within Host n Screening n Treatment n Control/Surveillance http: //www. nature. com/genomics/images/neisseria_200. jpg
 Transmission n Does not survive in the environment, must be transmitted through contact – Unprotected sex – Contact with eyes, mouth – Mother to child during birth Neonatal hyperacute purulent conjunctivitis http: //www. aafp. org/afp/980215 ap/morrow. html
Transmission n Does not survive in the environment, must be transmitted through contact – Unprotected sex – Contact with eyes, mouth – Mother to child during birth Neonatal hyperacute purulent conjunctivitis http: //www. aafp. org/afp/980215 ap/morrow. html
 Transmission n Transmissibility dependent on: – Strain – Male to female transmission more effective § Higher number of organisms present in male urethral discharge than female vaginal secretions http: //www. biology. arizona. edu/human_bio/problem_sets/stds/graphics/Gonorrhea. gif
Transmission n Transmissibility dependent on: – Strain – Male to female transmission more effective § Higher number of organisms present in male urethral discharge than female vaginal secretions http: //www. biology. arizona. edu/human_bio/problem_sets/stds/graphics/Gonorrhea. gif
 Structure n Diplococcus n Gram-negative n Fimbriae extend several micrometers from cell surface http: //textbookofbacteriology. net/BSRP. html
Structure n Diplococcus n Gram-negative n Fimbriae extend several micrometers from cell surface http: //textbookofbacteriology. net/BSRP. html
 http: //gsbs. utmb. edu/microbook/images/fig 97_2. JPG
http: //gsbs. utmb. edu/microbook/images/fig 97_2. JPG
 Systemic Infection http: //www. infocompu. com/adolfo_arthur/ingles/gonorrea. htm http: //www. dermnet. com/thumbnail. Index. cfm? module. ID=16&module Group. ID=234&group. Index=0&numcols=0
Systemic Infection http: //www. infocompu. com/adolfo_arthur/ingles/gonorrea. htm http: //www. dermnet. com/thumbnail. Index. cfm? module. ID=16&module Group. ID=234&group. Index=0&numcols=0
 Infection n N. gonorrhoeae attaches to mucosal cells via pili and other surface proteins http: //www. brown. edu/Courses/Bio_160/Projects 1999/av/gonorrhea. html n Induces production of inflammatory cytokines by epithelial cells
Infection n N. gonorrhoeae attaches to mucosal cells via pili and other surface proteins http: //www. brown. edu/Courses/Bio_160/Projects 1999/av/gonorrhea. html n Induces production of inflammatory cytokines by epithelial cells
 Infection http: //www. ncbi. nlm. nih. gov/books/bv. fcgi? rid=m med. figgrp. 898
Infection http: //www. ncbi. nlm. nih. gov/books/bv. fcgi? rid=m med. figgrp. 898
 n Evades Survival Within Host host immune system by changing surface proteins – Often asymptomatic infection http: //www. brown. edu/Courses/Bio_160/Projects 1999/av/gonorrhea. html n The Rdg. C protein is required for efficient pilin antigenic variation
n Evades Survival Within Host host immune system by changing surface proteins – Often asymptomatic infection http: //www. brown. edu/Courses/Bio_160/Projects 1999/av/gonorrhea. html n The Rdg. C protein is required for efficient pilin antigenic variation
 Antigenic Variation n Pilus promotes attachment of gonococcal cell to host epithelial cell – Must retain some consistency n Conserved N-terminal and variable Cterminal regions – Constant regions – Semi-variable regions – Hypervariable regions n Phase variation from piliated to nonpiliated
Antigenic Variation n Pilus promotes attachment of gonococcal cell to host epithelial cell – Must retain some consistency n Conserved N-terminal and variable Cterminal regions – Constant regions – Semi-variable regions – Hypervariable regions n Phase variation from piliated to nonpiliated
 Immune Memory n Infection history did not alter antibody levels in patients with current infection – Suggests immunological memory not induced by uncomplicated gonococcal infections n Local and systemic immune responses to gonococci extremely modest – Slight increase in serum immunoglobulin G (Ig. G) in infected males – Slight increase in serum Ig. A 1 antibodies in infected females
Immune Memory n Infection history did not alter antibody levels in patients with current infection – Suggests immunological memory not induced by uncomplicated gonococcal infections n Local and systemic immune responses to gonococci extremely modest – Slight increase in serum immunoglobulin G (Ig. G) in infected males – Slight increase in serum Ig. A 1 antibodies in infected females
 Survival Within Host n Pili, outer membrane proteins, lipopolysaccharides – – – Binding to epithelial surfaces Passage through epithelium Interaction with phagocytes Variations in outer membrane protein (P 1, Por) n Requires n – Carbon dioxide – Sulfur in form of cysteine – Iron http: //www. med. monash. edu. au/assets/images/mic robiology/gono. jpg
Survival Within Host n Pili, outer membrane proteins, lipopolysaccharides – – – Binding to epithelial surfaces Passage through epithelium Interaction with phagocytes Variations in outer membrane protein (P 1, Por) n Requires n – Carbon dioxide – Sulfur in form of cysteine – Iron http: //www. med. monash. edu. au/assets/images/mic robiology/gono. jpg
 Antimicrobial Resistance n Gonococcal strains resistant to: – Penicillins – Tetracyclines – Spectinomycin – Fluoroquinolones n Presently, ciprofloxacin and ofloxacin recommended by CDC for treatment
Antimicrobial Resistance n Gonococcal strains resistant to: – Penicillins – Tetracyclines – Spectinomycin – Fluoroquinolones n Presently, ciprofloxacin and ofloxacin recommended by CDC for treatment
 Biotechnology n Oligonucleotide chips now used to screen for antimicrobial resistance – Point mutations in the gyr. A and par. C genes § Determine the prevalence of ciprofloxacin-resistant strains n Results identical to sequencing results n Rapid and reliable analysis
Biotechnology n Oligonucleotide chips now used to screen for antimicrobial resistance – Point mutations in the gyr. A and par. C genes § Determine the prevalence of ciprofloxacin-resistant strains n Results identical to sequencing results n Rapid and reliable analysis
 Gonorrhea n Topic Overview n Biology of Neisseria gonorrhoeae – Survival Within Host n Screening n Treatment n Control/Surveillance http: //thailabonline. com/bacteria 7. htm
Gonorrhea n Topic Overview n Biology of Neisseria gonorrhoeae – Survival Within Host n Screening n Treatment n Control/Surveillance http: //thailabonline. com/bacteria 7. htm
Screening n “Gold Standard” – Nucleic acid amplification assays § Polymerase chain reaction n Cell culture to confirm diagnosis – Oxidase positive http: //education. med. nyu. edu/courses/microbiology/courseware/infect-disease/Gram_Neg_Bacilli 5. html
Screening n “Gold Standard” – Nucleic acid amplification assays § Polymerase chain reaction n Cell culture to confirm diagnosis – Oxidase positive http: //education. med. nyu. edu/courses/microbiology/courseware/infect-disease/Gram_Neg_Bacilli 5. html
 Types of Tests n Gram-Stained Smear – Sensitivity reduced in asymptomatic infections – Less that 50% sensitive as cell culture – Not useful in rectal infections http: //www. lahey. org/Medical/Infectious. Diseases/ID_Gonorrhea. asp
Types of Tests n Gram-Stained Smear – Sensitivity reduced in asymptomatic infections – Less that 50% sensitive as cell culture – Not useful in rectal infections http: //www. lahey. org/Medical/Infectious. Diseases/ID_Gonorrhea. asp
Types of Tests n Culture Based Systems – High degree of specificity – Expensive – Trained personnel – Media requirements – Presumptive identification http: //www. asu. edu/it/spotlight/archive/genesis/ § Growth on selective GC agar, gram stain, oxidase and superoxol positivity
Types of Tests n Culture Based Systems – High degree of specificity – Expensive – Trained personnel – Media requirements – Presumptive identification http: //www. asu. edu/it/spotlight/archive/genesis/ § Growth on selective GC agar, gram stain, oxidase and superoxol positivity
 Types of Tests n Antigen Detection and Enzyme Immunoassays – Extensively investigated § Low/high prevalence § Symptomatic/asymptomatic – Few to no situations for which this assay recommended § Because of antigenic variation http: //wfrc. usgs. gov/research/fish%20 populations/STMaule 5. htm
Types of Tests n Antigen Detection and Enzyme Immunoassays – Extensively investigated § Low/high prevalence § Symptomatic/asymptomatic – Few to no situations for which this assay recommended § Because of antigenic variation http: //wfrc. usgs. gov/research/fish%20 populations/STMaule 5. htm
 Types of Tests n DNA Probe Hybridization – Specific chemiluminescent label on probe – Available commercially – 85% sensitivity – 99% specificity http: //www. ebiotrade. com
Types of Tests n DNA Probe Hybridization – Specific chemiluminescent label on probe – Available commercially – 85% sensitivity – 99% specificity http: //www. ebiotrade. com
 Types of Tests n Nucleic (NAAT) Acid-Based Amplification Assays – 95% accurate – False positives due to specimen crosscontamination, environmental contamination http: //www. biologicalprocedures. com/bpo/arts/1/6/m 6. htm
Types of Tests n Nucleic (NAAT) Acid-Based Amplification Assays – 95% accurate – False positives due to specimen crosscontamination, environmental contamination http: //www. biologicalprocedures. com/bpo/arts/1/6/m 6. htm
 Current Screening n No test for samples from all major sites of gonococcal infection – Rapid – Inexpensive – Reliable n Such a test would improve case-finding – Efficient treatment – Disease management
Current Screening n No test for samples from all major sites of gonococcal infection – Rapid – Inexpensive – Reliable n Such a test would improve case-finding – Efficient treatment – Disease management
 Gonorrhea n Topic Overview n Biology of Neisseria gonorrhoeae – Survival Within Host n Screening n Treatment n Control/Surveillance http: //neisseria. org/ng/images/
Gonorrhea n Topic Overview n Biology of Neisseria gonorrhoeae – Survival Within Host n Screening n Treatment n Control/Surveillance http: //neisseria. org/ng/images/
 Treatment http: //www. cdc. gov/STD/treatment/4 -2002 TG. htm#Gonococcal
Treatment http: //www. cdc. gov/STD/treatment/4 -2002 TG. htm#Gonococcal
 Treatment n Fluoroquinolones Levofloxacin Ciprofloxacin http: //www. ncbi. nlm. nih. gov/books/bv. fcgi? rid=mmed. figgrp. 686 http: //www. alchemchina. com/products/apis_l. files/Levofloxacin. gif Ofloxacin http: //www. m-ww. de/pharmakologie/arzneimittel/antiinfektiva/antibiotika/ofloxacin. html
Treatment n Fluoroquinolones Levofloxacin Ciprofloxacin http: //www. ncbi. nlm. nih. gov/books/bv. fcgi? rid=mmed. figgrp. 686 http: //www. alchemchina. com/products/apis_l. files/Levofloxacin. gif Ofloxacin http: //www. m-ww. de/pharmakologie/arzneimittel/antiinfektiva/antibiotika/ofloxacin. html
 Treatment n Ceftriaxone (Rocephin®) – Single dose intramuscularly – Introduced as treatment in 1985 § Retained resistance – Beta-lactam antibiotic – Action against penicillinase http: //www. m-ww. de/pharmakologie/arzneimittel/antiinfektiva/antibiotika/ceftriaxon. html
Treatment n Ceftriaxone (Rocephin®) – Single dose intramuscularly – Introduced as treatment in 1985 § Retained resistance – Beta-lactam antibiotic – Action against penicillinase http: //www. m-ww. de/pharmakologie/arzneimittel/antiinfektiva/antibiotika/ceftriaxon. html
 Treatment n Possible co-infection with Chlamydia trachomatis Azithromycin Doxycycline http: //www. cbwinfo. com/Pharmaceuticals/Structures/Doxycycline. gif http: //www. bmb. leeds. ac. uk/mbiology/ug/ugteach/icu 8/images/antibiotics/azithromycin. gif
Treatment n Possible co-infection with Chlamydia trachomatis Azithromycin Doxycycline http: //www. cbwinfo. com/Pharmaceuticals/Structures/Doxycycline. gif http: //www. bmb. leeds. ac. uk/mbiology/ug/ugteach/icu 8/images/antibiotics/azithromycin. gif
 Vaccine n Hard to develop – No animal model n No immune memory to Neisseria gonorrhoeae – Antigenic variation strategy n Difficulty finding target common to all strains n Research continues to identify possible vaccine targets – DNA vaccines – Mucosal immunization
Vaccine n Hard to develop – No animal model n No immune memory to Neisseria gonorrhoeae – Antigenic variation strategy n Difficulty finding target common to all strains n Research continues to identify possible vaccine targets – DNA vaccines – Mucosal immunization
 Gonorrhea n Topic Overview n Biology of Neisseria gonorrhoeae – Survival Within Host n Screening n Treatment n Control/Surveillance http: //www. mediscan. co. uk/cfm/img_coll. cfm? action=sear ch&image. ID=020864&collection. ID=21&name=Electron%2 0 Micrographs&log=nk#
Gonorrhea n Topic Overview n Biology of Neisseria gonorrhoeae – Survival Within Host n Screening n Treatment n Control/Surveillance http: //www. mediscan. co. uk/cfm/img_coll. cfm? action=sear ch&image. ID=020864&collection. ID=21&name=Electron%2 0 Micrographs&log=nk#
 Prevention n Abstinence n Safe/”smart” sex n Barrier contraceptives n Educational programs n Reduce misuse of antimicrobials http: //www. pueblo. gsa. gov/cic_text/health/contracept/co ndom. gif
Prevention n Abstinence n Safe/”smart” sex n Barrier contraceptives n Educational programs n Reduce misuse of antimicrobials http: //www. pueblo. gsa. gov/cic_text/health/contracept/co ndom. gif
 Governmental Programs n Health Canada – Educational plans – STD Screening – Free STD clinics
Governmental Programs n Health Canada – Educational plans – STD Screening – Free STD clinics
 Governmental Programs n CDC Gonococcal Isolate Surveillance Project (GISP)
Governmental Programs n CDC Gonococcal Isolate Surveillance Project (GISP)
 Conclusions n More research – Reliable, fast screening – Preventative therapeutics n Non-biotechnological interventions n Prudent antimicrobial use http: //www. agma. med. uni-giessen. de/cfagma/andro/verz. dbm
Conclusions n More research – Reliable, fast screening – Preventative therapeutics n Non-biotechnological interventions n Prudent antimicrobial use http: //www. agma. med. uni-giessen. de/cfagma/andro/verz. dbm
 References n n n n Alary, M, 1997. National goals for the prevention and control of sexually transmitted diseases in Canada Communicable Disease Report, vol. 23 Sb. Barron, S, Peake, R, James, D, Susman, M, Kennedy, C, Singleton, M, Schuenke, S, 1996. Medical microbiology, 4 th Edition. The University of Texas Medical Branch at Galveston, TX. Bos, M, Tefsen, B, Voet, P, Weynants, V, van Putten, J, Tommassen, J, 2005. Function of neisserial outer membrane phospholipase a in autolysis and assessment of its vaccine potential. Infection and Immunity. 73(4): 2222 -31. Bowden, F, Tabrizi, S, Garland, S, Fairley, C, 2002. Sexually transmitted infections: new diagnostic approaches and treatments. MJA Practice Essentials — Infectious Diseases. 176 (11): 551 -557. Brooks, G, Lammel, C, 1989. Humoral immune response to gonococcal infections. Clinical Microbiology Review. 2(Suppl): S 5– 10. Centers for Disease Control and Prevention, 2005. STD facts and information Gonorrhea. National Center for HIV, STD, and TB Prevention, Division of Sexually Transmitted Diseases Prevention. http: //www. cdc. gov/nchstp/dstd/Gonorrhea. Info. htm last accessed: 3/29/05. Charnas, R, Then, R, 1988. Mechanism of inhibition of chromosomal beta- lactamses by third-generation cephalosporins. Reviews in Infectious Disease, 10(4): 752 -760. Chen, A, Boulton, I, Pongoski, J, Cochrane, A, Gray-Owen, S, 2003. Induction of HIV-1 long terminal repeat-mediated transcription by Neisseria gonorrhoeae. AIDS, 17(4): 625 -628. Fletcher, L, Bernfield , L, Barniak, V, Farley, J, Howell, A, Knauf, M, Ooi, P, Smith, R, Weise, P, Wetherell , M, Xie, X, Zargursky, R, Zhang, Y, Zlotnick G, 2004. Vaccine potential of the Neisseria meningitides 2086 lipoprotein. Infection and Immunity. 72(4): 2088 -2100. Forest K, Bernstein, S, Getzoff, E, Tribbick, S, Geysen, H, Deal, C, Tainer, J, 1996. Assembly and antigenicity of the Neisseria gonorrhoeae pilus mapped with antibodies. Infection and Immunity. 64(2): 644– 652. Fredlund, H, Falk, L, Jurstrand, M, Unemo, M, 2004. Molecular genetic methods for diagnosis and characterization of Chlamydia trachomatis and Neisseria gonorrhoeae: impact on epidemiological surveillance and interventions. Acta Pathologica, Microbiologica et Immunologica Scandinavica. 112(11 -12): 771 -84. Hamilton, H, Dominguez, N, Schwartz, K, Hackett, K, Dillard, J, 2005. Neisseria gonorrhoeae secretes chromosomal DNA via a novel type IV secretion system. Molecular Microbiology. 55(6): 1704 -21. Hedges, S, Mayo, M, Mestecky, J, Hook, E, Russell, M, 1999. Limited local and systemic antibody responses to Neisseria gonorrhoeae during uncomplicated genital infections. Infection and Immunity. 67(8): 3937 -3946. Jacoby, GA, 1994. Genetics of extended-spectrum beta- lactamase. Journal of Clinical Microbiology and Infectious Diseases, 13 Suppl 1: S 2 -11 Judson, F, Beals, B, Tack, K, 1986. Clinical experience with ofloxacin in sexually transmitted disease. Infection, 14(4): 309310. Title Slide picture: http: //www. visualsunlimited. com/browse/vu 197395. html
References n n n n Alary, M, 1997. National goals for the prevention and control of sexually transmitted diseases in Canada Communicable Disease Report, vol. 23 Sb. Barron, S, Peake, R, James, D, Susman, M, Kennedy, C, Singleton, M, Schuenke, S, 1996. Medical microbiology, 4 th Edition. The University of Texas Medical Branch at Galveston, TX. Bos, M, Tefsen, B, Voet, P, Weynants, V, van Putten, J, Tommassen, J, 2005. Function of neisserial outer membrane phospholipase a in autolysis and assessment of its vaccine potential. Infection and Immunity. 73(4): 2222 -31. Bowden, F, Tabrizi, S, Garland, S, Fairley, C, 2002. Sexually transmitted infections: new diagnostic approaches and treatments. MJA Practice Essentials — Infectious Diseases. 176 (11): 551 -557. Brooks, G, Lammel, C, 1989. Humoral immune response to gonococcal infections. Clinical Microbiology Review. 2(Suppl): S 5– 10. Centers for Disease Control and Prevention, 2005. STD facts and information Gonorrhea. National Center for HIV, STD, and TB Prevention, Division of Sexually Transmitted Diseases Prevention. http: //www. cdc. gov/nchstp/dstd/Gonorrhea. Info. htm last accessed: 3/29/05. Charnas, R, Then, R, 1988. Mechanism of inhibition of chromosomal beta- lactamses by third-generation cephalosporins. Reviews in Infectious Disease, 10(4): 752 -760. Chen, A, Boulton, I, Pongoski, J, Cochrane, A, Gray-Owen, S, 2003. Induction of HIV-1 long terminal repeat-mediated transcription by Neisseria gonorrhoeae. AIDS, 17(4): 625 -628. Fletcher, L, Bernfield , L, Barniak, V, Farley, J, Howell, A, Knauf, M, Ooi, P, Smith, R, Weise, P, Wetherell , M, Xie, X, Zargursky, R, Zhang, Y, Zlotnick G, 2004. Vaccine potential of the Neisseria meningitides 2086 lipoprotein. Infection and Immunity. 72(4): 2088 -2100. Forest K, Bernstein, S, Getzoff, E, Tribbick, S, Geysen, H, Deal, C, Tainer, J, 1996. Assembly and antigenicity of the Neisseria gonorrhoeae pilus mapped with antibodies. Infection and Immunity. 64(2): 644– 652. Fredlund, H, Falk, L, Jurstrand, M, Unemo, M, 2004. Molecular genetic methods for diagnosis and characterization of Chlamydia trachomatis and Neisseria gonorrhoeae: impact on epidemiological surveillance and interventions. Acta Pathologica, Microbiologica et Immunologica Scandinavica. 112(11 -12): 771 -84. Hamilton, H, Dominguez, N, Schwartz, K, Hackett, K, Dillard, J, 2005. Neisseria gonorrhoeae secretes chromosomal DNA via a novel type IV secretion system. Molecular Microbiology. 55(6): 1704 -21. Hedges, S, Mayo, M, Mestecky, J, Hook, E, Russell, M, 1999. Limited local and systemic antibody responses to Neisseria gonorrhoeae during uncomplicated genital infections. Infection and Immunity. 67(8): 3937 -3946. Jacoby, GA, 1994. Genetics of extended-spectrum beta- lactamase. Journal of Clinical Microbiology and Infectious Diseases, 13 Suppl 1: S 2 -11 Judson, F, Beals, B, Tack, K, 1986. Clinical experience with ofloxacin in sexually transmitted disease. Infection, 14(4): 309310. Title Slide picture: http: //www. visualsunlimited. com/browse/vu 197395. html
 n n n n n Leclercq, R, 2001. Overcoming antimicrobial resistance: profile of new ketolide antibacterial, telithromycin. Journal of Antimicrobial Chemotherapy, 48(T 1): 9 -23. Levy, S, Marshall, B, 2004. Antimicrobial resistance worldwide: causes, challenges, and responses. Nature Medicine Supplement. 10(12): 122 -128. Massari, P, Ram, S, Macleod, H, Wetzler, L, 2003. The role of porins in neisserial pathogenesis and immunity. Trends in Microbiology. 11(2): 87 -93. Merz, A, So, M, 2000. Interactions of pathogenic Neisseriae with epithelial cell membranes. Annual Review of Cell and Developmental Biology. Vol. 16: 423 -457. Moore, T, Sharples, G, Lloyd, R, 2004. DNA binding by the meningococcal rdg. C protein, associated with pilin antigenic variation. Bacteriology, 186(3): 870– 874. Nassif, X, So, M, 1995. Interaction of pathogenic neisseriae with nonphagocytic cells. Clinical Microbiology Review. 8(3): 376– 388. Naumann, M, Wessler, S, Bartsch, C, Weieland, B, Meyer, T, 1997. Neisseria gonorrhoeae epithelial cell interaction leads to the activation of the transcription factors nuclear factor k. B and activator protein 1 and the induction of inflammatory cytokines. Journal of Experimental Medicine, 186(2): 247 -258. Nusbaum, M, Wallace, R, Slatt, L, Konrad, E, 2004. Sexually transmitted infections and increased risk of co-infection with Human Immunodeficiency Virus. The Journal of the American Osteopathic Association, 104(12): 527 -535. Perrin, A, Nassif, X, Tinsley, C, 1999. Identification of regions of the chromosome of Neisseria meningitides and Neisseria gonorrhoeae which are specfici to the pathogenic Neisseria species. Infection and Immunity. 67(11): 6119– 6129. Price, G, Hobbs, M, Cornelissen , C, 2004. Immunogenicity of Gonococcal Transferrin Binding Proteins during Natural Infections. Infection and Immunity. 72(1): 277– 283. Rotchford, K, Strum, A, Wilkinson, D, 2000. Effect of coinfection with STDs and of STD treatment on HIV shedding in genital-tract secretions: systematic review and data synthesis. Sexually Transmitted Diseases, 27(5): 243 -248. Suzuki, K, Matsumoto, T, Murakami, H, Tateda, K, Ishnii, N, Yamaguchi, K, 2004. Evaluation of rapid antigen detection test for Neisseria gonorrhoeae in urine sediment for diagnosis of gonococcal urethritis in males. Journal of Infection and Chemotherapy, 10(4): 208 -211. Shang, S, Xia, L, Zhong, M, Zhang, J, Zhao, J, Gong, X, Mabey, D, Wang, Q, 2005. In vitro effects of spectinomycin and ceftriaxone alone or in combination with other antibiotics against Chlamydia trachomatis. Antimicrobial Agents Chemotherapy, 49(4): 1584 -1586. Taha, M, Marchal, L, 1990. Conservation of Neisseria gonorrhoeae pilus expression regulatory genes pil. A and pil. B in the genus Neisseria. Infection and Immunity, 58(12): 4145 -4148. Tapsall, J, 2001. Anitmicrobial resistance in Neisseria gonorrhoeae. World Health Organization. Virji, M, Heckels, J, 1985. Role of anti-pilus antibodies in host defense against gonococcal infection studied with monoclonal anti-pilus antibodies. Infection and Immunity. 49(3): 621 -628. Zhou, W, Du, W, Cao, H, Zhao, J, Yangs, S, Li, W, Shen, Y, Zhang, S, Du, W, Zhang, X, 2004. Detection of gyr. A and par. C mutations associated with ciprofloxacin resistance in Neisseria gonorrhoeae by use of oligonucleotide biochip technology. Journal of Clinical Microbiology. 42(12): 5819 -24.
n n n n n Leclercq, R, 2001. Overcoming antimicrobial resistance: profile of new ketolide antibacterial, telithromycin. Journal of Antimicrobial Chemotherapy, 48(T 1): 9 -23. Levy, S, Marshall, B, 2004. Antimicrobial resistance worldwide: causes, challenges, and responses. Nature Medicine Supplement. 10(12): 122 -128. Massari, P, Ram, S, Macleod, H, Wetzler, L, 2003. The role of porins in neisserial pathogenesis and immunity. Trends in Microbiology. 11(2): 87 -93. Merz, A, So, M, 2000. Interactions of pathogenic Neisseriae with epithelial cell membranes. Annual Review of Cell and Developmental Biology. Vol. 16: 423 -457. Moore, T, Sharples, G, Lloyd, R, 2004. DNA binding by the meningococcal rdg. C protein, associated with pilin antigenic variation. Bacteriology, 186(3): 870– 874. Nassif, X, So, M, 1995. Interaction of pathogenic neisseriae with nonphagocytic cells. Clinical Microbiology Review. 8(3): 376– 388. Naumann, M, Wessler, S, Bartsch, C, Weieland, B, Meyer, T, 1997. Neisseria gonorrhoeae epithelial cell interaction leads to the activation of the transcription factors nuclear factor k. B and activator protein 1 and the induction of inflammatory cytokines. Journal of Experimental Medicine, 186(2): 247 -258. Nusbaum, M, Wallace, R, Slatt, L, Konrad, E, 2004. Sexually transmitted infections and increased risk of co-infection with Human Immunodeficiency Virus. The Journal of the American Osteopathic Association, 104(12): 527 -535. Perrin, A, Nassif, X, Tinsley, C, 1999. Identification of regions of the chromosome of Neisseria meningitides and Neisseria gonorrhoeae which are specfici to the pathogenic Neisseria species. Infection and Immunity. 67(11): 6119– 6129. Price, G, Hobbs, M, Cornelissen , C, 2004. Immunogenicity of Gonococcal Transferrin Binding Proteins during Natural Infections. Infection and Immunity. 72(1): 277– 283. Rotchford, K, Strum, A, Wilkinson, D, 2000. Effect of coinfection with STDs and of STD treatment on HIV shedding in genital-tract secretions: systematic review and data synthesis. Sexually Transmitted Diseases, 27(5): 243 -248. Suzuki, K, Matsumoto, T, Murakami, H, Tateda, K, Ishnii, N, Yamaguchi, K, 2004. Evaluation of rapid antigen detection test for Neisseria gonorrhoeae in urine sediment for diagnosis of gonococcal urethritis in males. Journal of Infection and Chemotherapy, 10(4): 208 -211. Shang, S, Xia, L, Zhong, M, Zhang, J, Zhao, J, Gong, X, Mabey, D, Wang, Q, 2005. In vitro effects of spectinomycin and ceftriaxone alone or in combination with other antibiotics against Chlamydia trachomatis. Antimicrobial Agents Chemotherapy, 49(4): 1584 -1586. Taha, M, Marchal, L, 1990. Conservation of Neisseria gonorrhoeae pilus expression regulatory genes pil. A and pil. B in the genus Neisseria. Infection and Immunity, 58(12): 4145 -4148. Tapsall, J, 2001. Anitmicrobial resistance in Neisseria gonorrhoeae. World Health Organization. Virji, M, Heckels, J, 1985. Role of anti-pilus antibodies in host defense against gonococcal infection studied with monoclonal anti-pilus antibodies. Infection and Immunity. 49(3): 621 -628. Zhou, W, Du, W, Cao, H, Zhao, J, Yangs, S, Li, W, Shen, Y, Zhang, S, Du, W, Zhang, X, 2004. Detection of gyr. A and par. C mutations associated with ciprofloxacin resistance in Neisseria gonorrhoeae by use of oligonucleotide biochip technology. Journal of Clinical Microbiology. 42(12): 5819 -24.


